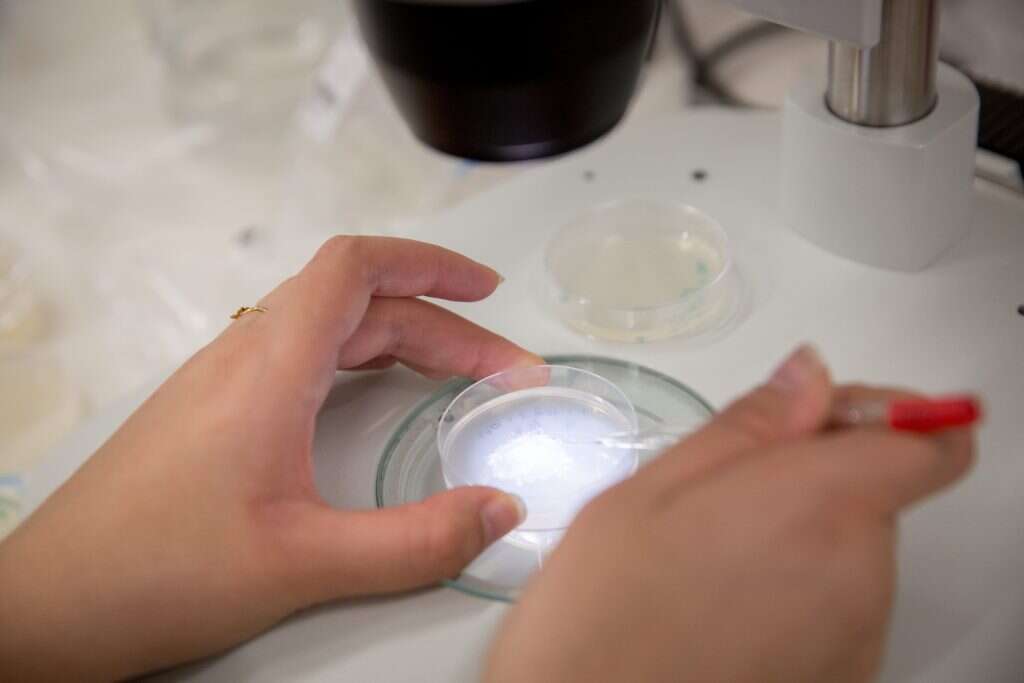
המעבדה בפקולטה למדעי הטבע בגבעת־רם. | מרים אלסטר, פלאש 90 המעבדה בפקולטה למדעי הטבע בגבעת־רם. | מרים אלסטר, פלאש 90

לפעמים, כשחם מדי, וטרדות היומיום מציפות, אני רק רוצה להיות תולעת. לחיות בטמפרטורה של 20 מעלות ולא לדאוג מכלום: רק לאכול, להתרבות ולמות. לו הייתי תולעת במעבדתו של ד"ר אלון זסלבר מהאוניברסיטה העברית, הייתי גם זוכה לבמה מכובדת ואולי אף לתהילת עולם; כל היום היו בוחנים אותי במיקרוסקופ משוכלל ויקר ("עכשיו קנינו, חצי מיליון דולר!") ומתפעלים מכל תנועה שלי.
במעבדה של זסלבר עוקבים אחרי תולעים קטנות, בגודל מילימטר בלבד. קוראים להן "סי אלגנס" (C. elegans), ובגופה של כל אחת מהן יש רק אלף תאים. לכן הגברת האלגנטית הספציפית הזאת, הנפוצה בכל העולם, היא חלומו של כל מהנדס. הרשת העצבית שלה, המונה כשליש מכלל התאים - 302, ליתר דיוק – מופּתה במלואה. המדענים יודעים בדיוק מהם הקשרים בין כל תא למשנהו, ולכל תא אף יש שם משלו. בעזרתה של סי אלגנס, היצור היחיד שפוענח באופן מפורט כזה, ניתן כיום לחקור כיצד מועבר מידע ברשת העצבים.
אלון זסלבר (44), נשוי ואב לשלושה בנים, נוסע בכל יום מביתו במושב ביצרון למעבדה שהוא עומד בראשה בגבעת־רם. הוא גדל בחולון, ובמכון ויצמן למד ביולוגיה מערכתית. "אנחנו רוצים להבין איך מערכות ביולוגיות מורכבות עובדות, ולשם כך אנחנו משלבים גישות שונות - ניסויים, פיתוח מודלים ואפילו משוואות", מסביר זסלבר את תחום המחקר שלו. "כך אנחנו יכולים לגלות בצורה מדויקת וכמותית מה היצור החי עושה".
הכי מעניין

ד"ר אלון זסלבר. | צילום: מרים אלסטר, פלאש 90
בדוקטורט שלו התמקד זסלבר בגנטיקה של חיידקים. לאחר מכן ביקש לדעת איך גנים ותאי עצב מכתיבים את ההתנהגות שלנו, ולשם כך הלך להתמחות במעבדה במכון הטכנולוגי של קליפורניה. "נניח שאנחנו שותים קפה", הוא מדגים את הנושא. "אם הוא חם מדי, תאי העצב הסנסוריים (החישתיים) שנמצאים ביד או בלשון, שולחים מידע למוח. התקשורת הזו נוצרת כאשר תא העצב מעביר כימיקלים לתא אחר. המוח מקבל את המסר, מפרש אותו, ושולח באותה דרך פקודה לאיבר: יש להימנע מהמגע הזה". אבל הקשרים במוח האנושי, אומר זסלבר, אינם פשוטים עד כדי כך. "למסר יכולות להיות כמה פרשנויות, וכל אחת מהן שולחת מידע או פקודה לתא אחר. הפקודה הפשוטה היא 'תעיף את היד', אבל יש מורכבות רבה יותר. למשל: המחשבה על קפה מזכירה לי כמה אני עייף ולמה, היא מזכירה לי את הפעם הקודמת שנכוויתי מקפה, ועוד ועוד. כל מסר סנסורי עושה המון דברים, והייתי שמח להבין את ההקשרים של הגירויים התחושתיים האלה. מכיוון שבמוח האנושי יש 100 מיליארד תאי עצב, וכל תא יכול להתקשר לאלף תאים אחרים, נראה לי שהתולעת הפשוטה הזאת תהיה מקום טוב יותר להתחיל להבין איך זה עובד".
מלבד זאת, אומר זסלבר, אפשר לערוך שינויים גנטיים בתולעים, ולבחון איך הדבר משפיע על תפקודן. "אני יכול להעלים גן או להוסיף גן חדש, וכך לבדוק מה הוא עושה. אפשר, נניח, ליצור בתולעת מוטציה שתגרום לה למחלה, ואז להשתיל לה גן אנושי שירפא אותה".
אתה גורם להן לחלות? אתה לא נקשר אליהן?
"אני לא באמת קשור לתולעים. הן כלי שעוזר לי להבין איך פועל עולם החי, כולל אנחנו".
על תבונה ורגישות
במעבדתו של זסלבר התחבטו בשאלה אם ליצור זעיר כמו סי אלגנס יכולה להיות תודעה. השאלה נותרה פתוחה מכיוון שאי אפשר באמת להגדיר תודעה בכלים מדעיים כמותיים, והפולמוס נשאר במישור המטאפיזי. "מה שכן, והראו את זה כבר לפנינו, התולעת הזאת יכולה ללמוד. למשל, בצורת הלימוד הפבלובית".
איוואן פבלוב, מדען רוסי שפעל בסוף המאה ה־19 וראשית המאה ה־20, נחשב לאבי המחקר של ההתניה הקלאסית: בניסוי המפורסם שעשה, הוא צלצל בפעמון בכל פעם שהאכיל את הכלבים שלו, וכעבור תקופה הראה שקול הצלצול גורם להם לרייר גם כשאין אוכל בסביבה. "היא ממש עושה את זה", אומר זסלבר על סי אלגנס. "מעניין אותנו לבדוק, בין השאר, מה הוא זיכרון, וכאן אנחנו יכולים לראות אילו תאי עצב השתנו בעקבות ההתניה הפבלובית".

איוואן פבלוב. | צילום: גטי אימג'ס
איך אתה עושה את זה בפועל?
"יש ריחות שהתולעים אוהבות ונמשכות אליהם. באופן מפתיע, ריח של פופקורן הוא אחד מהם. אם בלילה אנחנו מפזרים להן רק ריח, הן הולכות בכיוון שלו אבל לא מוצאות אוכל. הן נכנסות לסטרס, כי הן מורעבות. בבוקר הן כבר יודעות שהריח הזה לא אומר אוכל, אלא אומר סטרס".
עצור שנייה, מאיפה מגיע הריח הזה?
"אה, זה פשוט. מזמינים אותו באינטרנט, מחברת כימיקלים. את יכולה להזמין גם, אם את רוצה. אגב, יום אחד לא הצלחנו לעשות שום ניסוי, ולקח לנו המון זמן להבין מה קרה: מישהו הכין פופקורן במיקרוגל שכאן במטבח, והתולעים השתגעו. במקרה אחר, אחת הסטודנטיות השתמשה בקרם ידיים ריחני במיוחד, שמיסך את הריח של הכימיקל. שוב, שברנו את הראש למה התולעים לא מגיבות, עד שהבנו".
"חצי מהנוירונים של התולעת יושבים בראש שלה", ממשיך זסלבר להסביר את הניסויים הנעשים במעבדתו. "אנחנו משווים תולעים שלמדו לכאלה שלא למדו, וכך מוצאים את התאים שהזיכרון נשמר בהם. בשלב הבא אפשר לטפל בתולעים בעזרת כימיקל שישפיע על תאי העצב, או פשוט להרוג את התא, ולראות אם אפשר למחוק את הזיכרון".
איך הניסויים האלה משליכים על בני אדם?
"קחי למשל הלומי קרב, בעלי הפרעת דחק פוסט־טראומטית - ריח של אבק שרפה יכול להכניס אותם לסטרס. אנחנו רוצים לדעת מה הריח הזה עושה בזיכרון שלהם. השאיפה היא שנלמד מה השתנה בקשרים בין תאי העצב בעקבות הטראומה, והפך את הריח של אבק השרפה לטריגר לפלאשבקים. אנחנו מבינים שנוצר שינוי לטווח ארוך: הגנים בנוירונים כנראה נכנסו לפעולה ויצרו חלבונים שחיזקו קשרים בין תאי עצב, ואפילו בנו קשרים חדשים. אם אני רוצה לחסום קשר כזה, ולמנוע את היווצרות הזיכרון ארוך הטווח, אפשר לתת למטופל חומר שמעכב ייצור חלבונים".
במצבה הטבעי, הסי־אלגנס הזעירה חיה באדמה. אין לה עיניים, והיא מסתמכת על חוש הריח בלבד. "אחד הדברים שמעניינים אותי הוא איך התולעת יודעת להגיע למקומות. איך היא מחשבת לאן ללכת. כשאופים עוגה, למשל, כל הילדים מגיעים כי הם רואים איפה המטבח ואיפה התנור. אם חלילה הם לא היו יכולים לראות, הם היו הולכים לפי חוש הריח: ככל שהריח מתחזק, הילד יודע שהוא בכיוון הנכון. כדי לבדוק איך התולעת עושה את זה, שמנו אותה מתחת למיקרוסקופ, חשפנו אותה לכל מיני ריכוזי ריח, וחיכינו לראות מה קורה".
המחקר על מערכת הניווט של סי אלגנס פורסם בכתב־העת המדעי Nature Communications. "ראינו שתאי הנוירונים של התולעת מבצעים חישוב מתמטי ממש מגניב: כמה מהם חישבו אם הריח מתחזק, אבל לא רק זה - נוירון אחד חישב את ההפרשים, וזכר כנראה הפרשים קודמים. כלומר, הוא ידע להגיד שאם לאורך זמן לא חיזקתי את הריח משמעותית, כדאי לחפש קיצור דרך. המטרה היא לא רק לחסוך קצת זמן: במקרה של התולעת קיצור הדרך הוא קריטי, כי אם היא לא תגיע לאוכל, היא לא תשרוד. לכן יש נוירון נוסף, שמגיב לסימן של ההפרש. אם התולעת מקבלת 'קר' במשחק ה'חם־קר' שלנו, הוא יסמן שאסור להמשיך להסתכן. זה נוירון שמתפקד כמו מבוגר אחראי".
המחקר המתמקד בתולעים זוכה לפעמים לבוז ממדעני המוח האנושי, מודה זסלבר, "אבל כיום אנחנו רחוקים מלהבין אפילו איך תולעת בעלת שלוש מאות נוירונים מתנהגת. מחקרים על תולעים כאלה כבר קטפו כמה פרסי נובל. קשה להאמין שהיינו מגיעים לאותן תגליות במחקר על בני אדם".
"אנחנו משווים תולעים שלמדו לכאלה שלא למדו, וכך מוצאים את התאים שהזיכרון נשמר בהם. בשלב הבא אפשר לטפל בתולעים בעזרת כימיקל שישפיע על תאי העצב, או פשוט להרוג את התא, ולראות אם אפשר למחוק את הזיכרון"

ד"ר אלון זסלבר. | צילום: מרים אלסטר, פלאש 90
צלוחית תולעים בדואר
במעבדה של זסלבר עובדים בין שמונה לעשרה סטודנטים בכמה קבוצות, לפי נושאי המחקר שלהם. הם מתרוצצים ממקום למקום, מודדים, שוקלים, מתבוננים מבעד למיקרוסקופ. זסלבר לוקח אותי ממיקרוסקופ אחד למשנהו, מראה לי תולעים עם נוירונים זוהרים בצבעים פלואורסנטיים, שמתרוצצות על הצלחת.
"אנחנו קוראים את המחשבות של התולעת", הוא אומר. "אנחנו יודעים 'לצבוע' נוירון בצבע מסוים, ולומר שאם הוא פועל - התולעת תסתובב או תפנה אחורה. זה מעלה את השאלה של רצון חופשי: אולי התולעת חושבת שיש לה חופש בחירה, אבל אנחנו כבר צופים את הפעולה הבאה שלה, כי אנחנו רואים שהנוירון נכנס לפעולה".
המעבדה בפקולטה למדעי הטבע בגבעת־רם. | צילום: מרים אלסטר, פלאש 90
איך מתחילים מחקר כזה בכלל?
"העבודה שלנו הפוכה בדיוק לזו של מהנדס. במקום להמציא דבר חדש, אני מקבל משהו מופלא ומורכב, ואז אני מפרק את המכונה לגורמים ומנסה להבין את המנגנון שלה. בשביל זה צריך ללמוד עוד דברים חוץ מביולוגיה. כיועץ לסטודנטים לתואר ראשון בביולוגיה, אני תמיד ממליץ להם לשלב קורסים ותחומי לימוד נוספים, שייתנו להם כלים חשובים כשירצו לבצע מחקרים לתארים מתקדמים. זה גם מה שנחמד בפקולטה אצלנו בגבעת־רם - אנו מאפשרים לשלב ביולוגיה עם כל תחום אחר, כי כדי להבין מערכות מורכבות יש צורך ביכולות מגוונות.
"מה שאנחנו עושים דומה קצת לעבודה של בלש. כל פרק בסדרה 'חוק וסדר' מתחיל בזירת הפשע, ומובן שהאדם הראשון שחושדים בו הוא לא האשם, כי אז איפה העניין? רק אחרי שורה של פעולות נמרצות מגלים את הפושע, ואם זה מישהו שלא חשבנו עליו בכלל, ההפתעה גדולה. ככה גם במדע. בתחילת המחקר יש לנו מעט מידע לגבי האמת. כל ניסוי הוא עוד פיסת מידע, מוצג לטיעון במשפט, אם תרצי. כל פיסה כזו מאפשרת לנו לתכנן את הצעד הבא כדי לחשוף פרטים נוספים. בסוף צריך להרכיב את התמונה השלמה, וככל שהיא יותר מפתיעה, כך גובר הריגוש מהגילוי. בסדרת הטלוויזיה הפושע נתפס בתוך כמה ימים, אבל במדע זה לוקח שנים".
וכמו הבלשים, גם החוקרים נמצאים בלחץ מתמיד לפרסם את תוצאות החקירה.
זסלבר מעדיף בהקשר הזה דימוי אחר: "גם סטטיק ובן־אל, למשל, צריכים להוציא שיר חדש פעם בכמה זמן, כדי להישאר בתודעה. שימי תבורי לא יצא עם שיר חדש כבר די הרבה זמן, ולכן הוא פחות רלוונטי. כמו מדען שלא מפרסם מחקרים חדשים, הוא פחות אטרקטיבי. לשניהם זה יכול להיות קריטי לקריירה. על המדען ליצור הד בקהילה המדעית כדי לקבל מימון. העוגה מוגבלת, ואנחנו כל הזמן מתחרים בינינו על הפרוסה שתממן את המחקר הבא. כדי לקבל את המימון הזה צריך רעיון ממש טוב ורזומה של מצליחן".

סטטיק ובן־אל תבורי. | צילום: קוקו
זה מה שדרוש לחוקר הראשי במעבדה. בפועל, את הניסויים עצמם עורכים הסטודנטים. "התפקיד שלי הוא להדריך אותם, לחשוב יחד איתם על הניסוי ועל הפרשנות של התוצאות שמתקבלות. אבל כדי שהראש של הסטודנט יהיה נתון 24 שעות ביממה רק במחקר, ללא טרדות פרנסה, אני צריך לגייס כספים למלגות. זה מוסיף מתח. פתאום זאת לא רק הפרנסה שלי, אלא גם של עשרה סטודנטים".
הוא מלא הערכה לסטודנטים במעבדתו, ובפקולטה למדעי הטבע בכלל. "הם מדהימים. לפעמים אני מרגיש שכל מה שאני צריך לעשות זה רק להסיר דאגה מליבם, לוודא שיהיה להם שקט כלכלי ושיעמוד לרשותם ציוד מחקר מתקדם - והם כבר יוכלו עצמאית לעוף קדימה. יצא לי לעבוד חמש שנים במכון מחקר מוביל בארה"ב, שמסנן לתוכו את הסטודנטים הטובים ביותר מכל העולם, ולא הייתי מחליף אף אחד מהסטודנטים שלי במישהו שהכרתי שם. אני אומר להם שאני מקבל רק סטודנטים שהם טובים ממני. חושבים שאני צוחק, אבל אני לא. רק חשוב שידעו שהמדע הוא מרתון, ריצה למרחקים ארוכים. מעבר לחוכמה צריך המון נחישות ודבקות במשימה. וכן, אני מודה, גם מזל הוא מרכיב חשוב למתכון מנצח".
התחרות בין החוקרים ברחבי העולם היא לא רק כלכלית. "המעבדות של האוניברסיטאות ב'ליגת הקיסוס', שהן המובילות בעולם, חוקרות דברים דומים או זהים. הרבה פעמים אני מעדיף לא לדעת מה החוקרים המקבילים לי עושים, אלא ללכת עם האינטואיציות שלי. כשאני חושב על המתחרים, באופן טבעי אני עושה אותם הדברים שהם עושים, במקום להתמקד במה שנראה לי מעניין באמת. זאת לא דרך נכונה, כי תמיד יש מספיק מקום לפרסם תגליות שונות על אותו נושא".
יש קנאת סופרים?
"כן. לגמרי. ועדיין, הקהילה קולגיאלית, כי באמת יש לנו מטרה משותפת, ויש חדווה בגילוי. כשמופיע מאמר טוב של מתחרה, אני שמח על ההתקדמות. גילוי ממצאים חדשים מדהים אותי. רוב החוקרים שמחים אם נוצר איזה כלי חדש או נמצא זן של תולעים שמקדם את המחקר העולמי. אנחנו גם משתפים בינינו את הידע".
באיזו צורה?
"אנחנו שולחים זה לזה תולעים. אפשר לשלוח צלחות תולעים ב'פדקס', עושים את זה כל הזמן. יותר מזה, בארה"ב קיים 'בנק' של תולעים. יש בו אלפי זנים עם מוטציות בגנים שונים, ואפשר להזמין משם משלוחים. שבעה דולרים לכל זן".
טוב, זה ממש דוחה.
"מתרגלים. התולעים האלו לא מזיקות. הן אוהבות 20 מעלות ולחות. אם הן רק מטפסות בטעות על דפנות הצלחת, הן מתייבשות ומתות. על הגוף שלנו הן לא יכולות לשרוד. בטבע אין מקום לטעויות, וכדי למנוע אותן האבולוציה דואגת לפיתוח מנגנוני הישרדות מתוחכמים. זה היופי בטבע, וזה מה שאני הכי נהנה לחקור: אילו מנגנונים נותנים מענה לקשיי היומיום ומאפשרים לנו לשרוד".
במה יעסוק המחקר הבא שלך?
"עוד לא החלטתי. בכל פעם אני מחפש משהו חדש. כרגע מדליק אותי לבדוק אם תולעים הן 'רציונליות'. ברור שאנחנו בני האדם לא ניחנו ביכולת הזו, ולכן שוב ושוב אנו מקבלים החלטות לא הגיוניות. הכיף כאן בפקולטה הוא שיש חופש, ואם רעיון נראה לך טוב ויש לו מימון, אתה בא ומממש אותו. אין מישהו שאומר לי 'לא, את זה אתה לא יכול לחקור'. קשה לי שאומרים לי מה לעשות. אולי התגלגלתי לכאן כי אני אוהב את החופש הזה".
לתגובות: dyokan@makorrishon.co.il
